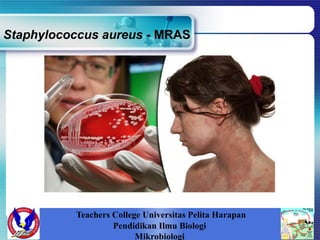
Staphylococcus aureus - MRAS
Teachers College Universitas Pelita Harapan
Pendidikan Ilmu Biologi
Mikrobiologi

Tiga dokumen tersebut membahas tentang berbagai bakteri patogen dan penyakit yang ditimbulkannya. Dokumen pertama membahas tentang bakteri Bacillus anthracis yang menyebabkan penyakit anthrax, bakteri Clostridium perfringens yang menyebabkan gastroenteritis, dan bakteri Staphylococcus aureus yang menyebabkan infeksi kulit dan jaringan. Dokumen kedua lebih spesifik membahas tentang anatomi, klasifikasi, dan mekanisme kerja bakteri Bac